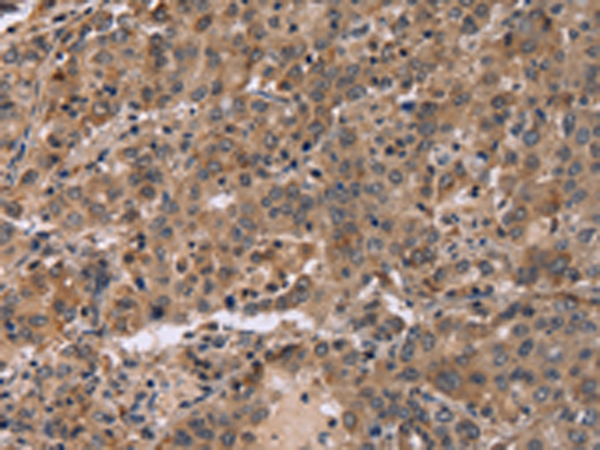

|
Background: |
FAM107B is a 131 amino acid protein that is encoded by a gene that maps to human chromosome 10, which contains over 800 genes and 135 million nucleotides, making up nearly 4.5% of the human genome. PTEN is an important tumor suppressor gene located on chromosome 10 and, when defective, causes a genetic predisposition to cancer development known as Cowden syndrome. The chromosome 10 encoded gene ERCC6 is important for DNA repair and is linked to Cockayne syndrome which is characterized by extreme photosensitivity and premature aging. Tetrahydrobiopterin deficiency and a number of syndromes involving defective skull and facial bone fusion are also linked to chromosome 10. As with most trisomies, trisomy 10 is rare and is deleterious. |
|
Applications: |
ELISA, IHC |
|
Name of antibody: |
FAM107A |
|
Immunogen: |
Fusion protein of human FAM107A |
|
Full name: |
family with sequence similarity 107, member A |
|
Synonyms: |
DRR1; TU3A |
|
SwissProt: |
O95990 |
|
ELISA Recommended dilution: |
2000-5000 |
|
IHC positive control: |
Human liver cancer and human colon cancer |
|
IHC Recommend dilution: |
50-200 |
購物車
購物車 幫助
幫助
 021-54845833/15800441009
021-54845833/15800441009
